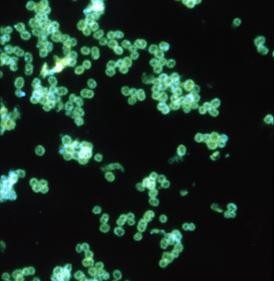

Материал: Литусов_Пиогенные кокки
Диссеминированная гонококковая инфекция возникает при гонококковой бактериемии. Диссеминация сопровождается петехиальными или пустулезными высыпаниями на коже, артралгией, артритом, эндокардитом, менингитом.
Особое значение имеет гонорея новорожденных. До 50% новорожденных заражается гонореей от больной матери при прохождении через родовые пути. В этом случае развивается офтальмия новорожденных (бленнорея, гонобленнорея, неонатальная гонококковая инфекция). Офтальмия новорожденных обнаруживается у ребенка на 2-3 день после рождения. Вначале она проявляется водянистыми желтоватыми выделениями из глаз. Через сутки отмечается сильная отечность и покраснение век, а выделения становятся мутными. Еще через 4-5 дней краснота век уменьшается, выделения приобретают гнойный характер (рисунок 2.42).


Рисунок 2.42 - Офтальмия новорожденных. Заимствовано из Интернет-ресурсов.
В этот период в процесс может вовлекаться роговая оболочка с образованием язв, на месте которых формируются рубцы, что может привести к слепоте.
Иммунитет после перенесенной гонореи практически отсутствует, поэтому могут регистрироваться повторные заболевания.
Лабораторная диагностика. В зависимости от локализации патологического процесса материалом для исследования служит гнойное отделяемое из уретры, влагалища, шейки матки, прямой кишки, глотки, с конъюнктивы глаза, а также сыворотка крови. При диагностике гонококковой инфекции применяют бактериоскопический, бактериологический (культуральный), серологические и молекулярно-биологические методы.
Бактериоскопическое исследование является наиболее распространенным методом диагностики гонореи, особенно у мужчин. При этом готовят два мазка, один из них окрашивают метиленовым синим, а другой - по Граму. При окраске метиленовым синим на фоне лейкоцитов и эпителиальных клеток, цитоплазма которых окрашена в бледно-голубой цвет, выделяются кокки интенсивно синего цвета. В мазке, окрашенном по Граму, на розовом фоне протоплазмы лейкоцитов выделяются гонококки ярко-розового цвета. В окрашенных препаратах наблюдается незавершенный фагоцитоз (рисунок 2.43).


а б
Рисунок 2.43 - Гонококки в гнойном отделяемом (незавершенный фагоцитоз), окраска метиленовым синим (а) и по Граму (б). Стрелками указаны микробные клетки. Заимствовано из Интернет-ресурсов.
Для дифференцировки гонококков от других грамотрицательных бактерий применяют реакцию иммунофлюоресценции (РИФ), при которой мазки обрабатывают противогонококковыми антителами, мечеными флюоресцентным красителем (рисунок 2.44).
Рисунок 2.44 – Иммунофлюоресцентная микроскопия гонококков. Заимствовано из Интернет-ресурсов.
Иммунофлюоресцентный метод позволяет выявлять гонококки при наличии в исследуемом материале ассоциаций микроорганизмов.
Бактериологическое (культуральное) исследование проводят при отрицательных результатах бактериоскопического исследования, при выявлении подозрительных на гонококк бактерий и для установления излеченности гонореи. Этот метод позволяет выявлять гонококки в 1,5-4 раза чаще, чем микроскопическое исследование. Посев материала производят сразу после отбора на сывороточный или асцитический агар. При невозможности посева после сбора материала используют транспортные среды (среда Стюара, транспортная среда в модификации ЦКВИ). Добавление к среде ристомицина и полимиксина М (10 ЕД/мл) значительно повышает высеваемость гонококков. Посевы инкубируют в атмосфере углекислого газа (10%).
Серологический метод используют при хронической гонорее, а также в случае отсутствия у больного выделений. В качестве серологического метода используют РСК (реакцию Борде-Жангу). Реакция становится положительной с 3-4 недели заболевания. При острой форме болезни она положительна у 35% больных, при хронической форме - у 65% (слабоположительная у 100%). В качестве антигена
для РСК применяют гоновакцину или антиген из убитых гонококков. Однако
реакция Борде-Жангу имеет вспомогательное значение, она непригодна для доказательства гонококковой инфекции и установления излеченности. Поэтому в последние годы эта реакция используется редко.
Иммуноферментный анализ позволяет определять антигены гонококка. Он является дополнительным диагностическим методом для обнаружения возбудителя.
В настоящее время для диагностики гонореи рекомендована полимеразная цепная реакция (ПЦР). Для забора материала используются эндоцервикальные, влагалищные тампоны и мужские уретральные тампоны. Методом ПЦР можно исследовать и мочу. Этот метод не рекомендован для исследования материала из ротоглотки и прямой кишки в связи с возможностью перекрестных реакций с другими нейссериями. С помощью ПЦР можно одновременно определять наличие в исследуемых образцах гонококков и хламидий.
Из числа молекулярно-биологических методов используется также ЛЦР (лигазная цепная реакция). Она также позволяет одновременно выявлять в пробах наличие гонококков и хламидий.
Лечение гонококковой инфекции зависит от формы заболевания. При острой и подострой гонорее применяют антибиотики группы пенициллина. Однако в последние годы практически все штаммы гонококков являются устойчивыми к пенициллинам. Кроме того, все чаще встречаются штаммы, обладающие устойчивостью к фторхинолонам (QRNG). Поэтому для лечения гонореи используют другие антибиотики. Эффективной считается комбинация азитромицина с цефтриаксоном.
Через 5-7 дней антибиотикотерапии воспалительные явления уменьшаются, выделения становятся скудными, гонококки в них не обнаруживаются. По истечении 7-10 дней определяют излеченность заболевания.
При хронической гонорее применяют специфическую (гоновакцина) или неспецифическую (пирогенал) иммунотерапию и местное воздействие на пораженный орган. После такого воздействия в стационарных условиях проводят курс терапии повышенными дозами антибиотиков.
Для контроля излеченности ранее использовали провокации химическим, механическим, алиментарным или термическим методами. После провокации через 24, 48 и 72 часа исследовали выделения. При отсутствии после провокации гонококков в мазках и посевах больных оставляли для диспансерного наблюдения. Через месяц повторно проводили провокацию и уретроскопию. Если в течение этого срока возбудитель и клинические проявления болезни отсутствовали, то таких лиц снимали с диспансерного учета. В настоящее время в России в соответствии со стандартом оказания медицинской помощи больным гонококковой инфекцией методы провокации не используются. Контроль излеченности проводят через 2 и 14 дней после окончания лечения по клинико-микробиологическим критериям.
Профилактика гонококковой инфекции включает следующие мероприятия:
активное выявление и лечение больных и их половых партнеров с последующим контролем на излеченность;
обязательное обследование декретированных групп населения (работники детских дошкольных учреждений и общепита) перед поступлением на работу и в последующем через каждые три месяца;
обязательная первичная обработка новорожденного с внесением за веки тетрациклиновой или эритромициновой мази для профилактики бленнореи (рисунок 2.45).

Рисунок 2.45 – Первичная обработка новорожденных. Заимствовано из Интернет- ресурсов.
Основное внимание в профилактике гонококковой инфекции принадлежит санитарно-просветительной работе, направленной на пропаганду здорового образа жизни и исключение случайных половых связей.
Средства специфической профилактики гонореи отсутствуют.
Вопросы для контроля усвоения материала
Таксономическое положение, морфологические, тинкториальные, культуральные и биохимические свойства гонококков.
Факторы патогенности и патогенез гонореи.
Клинические проявления гонореи.
Принципы лечения гонореи.
Методы профилактики гонореи.
Тренировочные тесты
Гонококки относятся к роду (один правильный ответ):
Staphylococcus
Streptococcus
Micrococcus
Enterococcus
Neisseria
К роду Neisseria относятся следующие бактерии (несколько правильных ответов):
клостридии
гонококки
менингококки
йерсинии
энтерококки
Возбудителем бленнореи является (один правильный ответ):
Streptococcus pyogenes
Neisseria meningitidis
Neisseria gonorrhoeae
Staphylococcus aureus
Staphylococcus epidermidis
Характерные признаки Neisseria gonorrhoeae (несколько правильных ответов):
подвижность
образование спор
способность размножаться в нейтрофилах
способность инфицировать плод при прохождении через родовые пути матери
грамположительная окраска
Какой фактор определяет способность гонококка инфицировать эпителий мочеиспускательного канала (один правильный ответ)?
ферменты, расщепляющие иммуноглобулины
капсульные полисахариды
способность размножаться внутри клеток
пили
цитотоксин
Факторы патогенности гонококка (несколько правильных ответов):
экзотоксины
жгутики
пили
белки наружной мембраны
споры
Адгезины гонококка (несколько правильных ответов):
пили
IgA-протеаза
жгутики
белки наружной мембраны
пептидогликан
Антифагоцитарные факторы гонококка (один правильный ответ):
пили
капсула
белки наружной мембраны
лейкоцидины
плазмокоагулаза
Протективные антигены гонококка (один правильный ответ):
капсульные полисахариды
пили
белки наружной мембраны
экзотоксины
соматический
Для культивирования гонококка используют (один правильный ответ):
сывороточный агар
желточно-солевой агар
висмут-сульфитный агар
среду Плоскирева
среду Левина
Источники инфекции при гонореи (один правильный ответ):
домашние животные
предметы обихода
медицинский инструментарий
больные
бактерионосители
Механизм передачи гонококковой инфекции (один правильный ответ):
фекально-оральный
контактный
аэрогенный
через укус насекомых
трансплацентарный
Путь передачи гонококковой инфекции (один правильный ответ):
водный
половой
пищевой
инъекционный
шприцевой
Входными воротами для гонококка является (несколько правильных ответов):
слизистая мочеполовых путей
поврежденная кожа
неповрежденная кожа
конъюнктива
слизистая тонкой кишки
Входными воротами для Neisseria gonorrhoeae является (один правильный ответ):
слизистая тонкой кишки
поврежденная кожа
слизистая прямой кишки
неповрежденная кожа
слизистая желудка
Положения, справедливые для гонококковой инфекции (один правильный ответ):
прочный постинфекционный иммунитет
возможность перехода в хроническую форму
возможность трансплацентарного инфицирования
возможность вторичных инфекций
наличие средств иммунопрофилактики
Методы микробиологической диагностики острой гонореи (один правильный ответ):
микроскопический, бактериологический
бактериологический, биологический
биологический, серологический
серологический, аллергический
биологический, аллергический
Основным методом диагностики хронической гонореи является (один правильный ответ):
бактериологический
бактериоскопический
биологический
серологический
кожно-аллергический
Средства специфической профилактики гонореи (один правильный ответ):
антибиотики
живая вакцина
не разработаны
убитая вакцина
химическая вакцина
Средства лечения гонореи (один правильный ответ):
пробиотики
иммуноглобулины
антибиотики
не разработаны
живая вакцина
Правильные ответы: 1.5; 2.2, 2.3; 3.3; 4.3, 4.4; 5.4; 6.3, 6.4; 7.1, 7.4; 8.2; 9.3; 10.1; 11.4;
12.2; 13.2; 14.1, 14.4; 15.3; 16.2; 17.1; 18.4; 19.3; 20.3.